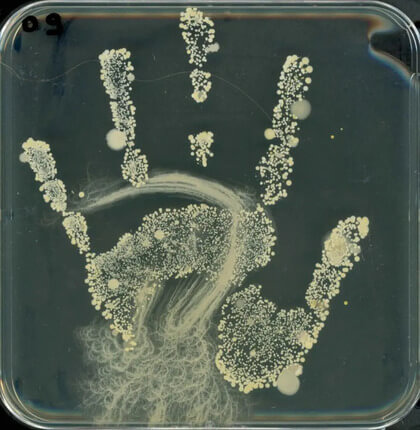

Schools and Educators
Raising aspirations
We want Exeter Science Centre to be an invaluable resource for local schools and educators: to help supplement the curriculum, raise aspirations, boost enthusiasm for STEMM (Science, Technology, Engineering, Maths and Medicine) and support local teachers and educators.
We have run a number of projects and events in schools and alternative education settings and always freely share the resources we produce. Have a look at our resources + upcoming events & opportunities below.
To stay updated, subscribe to our Schools and Educators Newsletter and follow us on social media!

Tackling eco-anxiety
We’ve worked with psychologists at the University of Exeter to provide resources on eco-anxiety, including a Shorts video series and infographic.
With these same researchers, we’ve also produced resources on maths anxiety – below!


Tackling maths anxiety
We’ve worked with psychologists at the University of Exeter to provide resources on maths anxiety for both students and teachers.
Find out what maths anxiety is, how to tackle it, and how teachers can support students at the link below.
Hello microbes!
This 1-lesson resource was designed for Key Stage 1 children to learn about microbes. It was designed in collaboration with Dr Nela Nikolic – a microbiologist at the University of Exeter, with funding from the Translational Research Exchange @ Exeter (TREE) and the Wellcome Trust.
We explore what microbes are, how we couldn’t live without them, how good microbes help us to fight bad microbes and how bacteria defend themselves against viruses.
The teacher guide and presentation are available at the link below.

Operation Earth
We were delighted to be one of the science centres that took part in the Operation Earth programme, designed and funded by the Natural Environment Research Council (NERC) and Association for Science and Discovery Centres. Our Operation Earth tour was generously funded by the Adrian Swire Charitable Trust. All the digital resources for the project are freely available on the Operation Earth website, and the resources we’ve made (including the project’s impact report) are accessible via the link below.
Using light to detect cancer
In this 1-lesson, hands-on workshop, your students can learn how physicists at the University of Exeter are detecting oesophageal cancer, in their research funded by Cancer Research UK.
We explore simple harmonic oscillators, travelling waves, sound waves in solids, and electromagnetism. Most suitable for KS5.
All the learning resources, including a teacher guide, student worksheet and short demo guides, are available at the link below.


ESC Live: Energy and Waste
In this project funded by the IET & IMechE, we visited energy generation facilities, meeting engineers from across the South West and streamed the visits live to local schools!
We’ve produced resources for each episode – and you can access them all at the link below.
COVID-19 Vaccine: ask the experts
We have produced a special set of YouTube videos where the experts answer questions from school students. Thanks to all the students and schools that have sent in their questions!
You can find the videos at the link below:

We don’t currently have any open opportunities, though we’re working hard to bring in project funding to provide workshops in the region, as well as grow our capacity to provide workshops more regularly. Please sign up to our newsletter and follow us on social media to keep posted (and to register your interest in our work).
How we prioritise schools for our projects and activities
We’re trying to have the biggest impact we can with our limited resources – so we prioritise underserved audiences who would benefit most from taking part in our activities.
We try to prioritise schools and education settings located in areas that rank between 1-5 in the Indices of Multiple Deprivation (2025), or that have a wide catchment including more deprived areas, or are rurally isolated, along with:
– a higher proportion of students on free school meals,
– lower progression rates to higher education.
We also aim to prioritise schools and education settings that we have not previously worked with.
Stay tuned for updates & share your views: